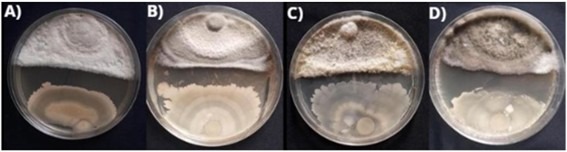
Halo de inibição

Produtos Biológicos: O Que São e Por Que Estão Transformando a Agricultura

Os insumos biológicos, também denominados bioinsumos, produtos biológicos ou bioprodutos, são produtos ou processos agroindustriais desenvolvidos a partir de enzimas, extratos de plantas ou microrganismos, macrorganismos (invertebrados), metabólitos secundários e feromônios. Eles são utilizados no controle biológico de pragas ou doenças, na nutrição de plantas, como promotores de crescimento, mitigadores de estresses bióticos e abióticos e substitutos de antibióticos (Embrapa, s.d.).
Considerando a versatilidade dos produtos biológicos na agricultura, esses bioinsumos tem sido cada vez mais utilizados para Performance de Plantas ou “Plant Performance” visando elevar o potencial produtivo da cultura.
O Plant Performance é um termo utilizado para referir-se ao potencial produtivo da planta, abrangendo sua capacidade em realizar processos fisiológicos, e a interação desses processos com o crescimento, desenvolvimento e produtividade da cultura.
Tendo em vista que há uma lacuna de produtividade entre o potencial produtivo e a produtividade atual, relacionada a influência de fatores bióticos e abióticos (Tagliapietra et al., 2022), o uso de produtos biológicos tem sido uma alternativa para promover o aumento da produtividade a um baixo custo, e mitigar o efeito de estresses sobre as culturas agrícolas.
Alguns produtos biológicos a exemplo dos fitormônios como auxinas, citocininas e giberelinas, podem ser empregados em culturas como soja para estimular o crescimento e desenvolvimento vegetal, alterando a arquitetura das plantas em pról do aumento da interceptação da radiação solar e aumento do desenvolvimento do sistema radicular visando explorar um maior volume de solo. Microrganismos como Bacillus e Trichoderma são frequentemente utilizados como antagonistas de doenças, promotores do crescimento e solubilizadores de nutrientes, favorecendo o desenvolvimento da planta sob condições adversas e aumentando sua performance no campo.
Em culturas como soja, milho e outras mais, o uso de produtos biológicos têm se tornado praticamente inevitável para o aumento da produtividade de maneira sustentável. Bactérias fixadoras de nitrogênio (Bradyrhizobium spp.) associadas a bactérias promotoras do crescimento (Azospirillum brasilense) tem contribuído efetivamente para o aumento da produtividade da soja, chegando a alavancar em até 25,4% a produtividade da soja coinoculadas com essas bactérias em relação a soja não coinoculadas (Araujo et al., 2025).
Figura 1. Efeitos da coinoculação de A. brasilense na produtividade de grãos de soja. Os dados representam os valores médios de todos os locais de campo em Rio Verde (GO), Indiara (GO), Pindorama (SP) e Mandaguaçu (PR) (Araujo et al., 2025).
 ECR = Região edafoclimática brasileira; NI = Não inoculado; NI + N = Não inoculado + Nitrogênio; Brady = Bradyrhizobium SEMIA 5079 (B. japonicum) + SEMIA 5080 (B. diazoefficiens); Azo = A. brasilense ; Azo Mix = A.brasilense IH1 + HM053 + HM210. Adaptado: Araujo et al. (2025)
ECR = Região edafoclimática brasileira; NI = Não inoculado; NI + N = Não inoculado + Nitrogênio; Brady = Bradyrhizobium SEMIA 5079 (B. japonicum) + SEMIA 5080 (B. diazoefficiens); Azo = A. brasilense ; Azo Mix = A.brasilense IH1 + HM053 + HM210. Adaptado: Araujo et al. (2025)
Na cultura do milho, a inoculação da cultura com bactérias do gênero Azospirillum tem contribuído para o aumento da produtividade e tolerância das plantas a condições de estresse.
Nesse cenário, esses agentes biológicos atuam estimulando o crescimento e desenvolvimento radicular das plantas, aumentando sua capacidade em explorar o solo e também resistir a estresses por déficit hídrico (figura 2). Essas características contribuem para o aumento da performance da planta, aumentando sua capacidade fotossintética e consequentemente produção de fotoassimilados e produtividade. Pesquisas demonstram que o ganho médio de produtividade do milho inoculado com estirpes de Azospirillum pode chegar a 24% em comparação ao milho não inoculado (Hungria, 2011).
Assim como Azospirillum, as bactérias do gênero Bacillus também atuam no crescimento vegetal, mas com maior versatilidade, também podem exercer papel no manejo de doenças, assim como o fungo Trichoderma, atuando como antagonistas no desenvolvimento de patógenos. De acordo com Salvadori et al. (2024), o uso de bioprodutos a base de Bacillus amyloliquefaciens, possibilita a redução substancial do crescimento miceliar de fungos como C. sojina, C. cassicola, S. glycines e C. truncatum, sendo uma interessante opção para integrar o manejo de doenças.
Figura 2. Halo de inibição demonstrado por Bacillus amyloliquefaciens sobre os fitopatógenos foliares C. sojina, C. cassicola, S. glycines e C. truncatum (respectivamente), aos sete dias após implantação do experimento.
Salvadori et al. (2024)
O controle biológico de pragas envolve o uso de fungos, bactérias, parasitoides e macroorganismos, provenientes de populações naturais do solo ou introduzidos nos sistemas de produção. Esses agentes têm contribuído significativamente para a redução das populações de pragas, especialmente quando integrados ao manejo integrado de pragas (MIP), atuando como ferramentas complementares ao controle químico.
Entre os microrganismos utilizados, destaca-se a bactéria entomopatogênica Bacillus thuringiensis, amplamente empregada em biotecnologias Bt para o controle de lagartas em diversas culturas agrícolas. Outros agentes biológicos incluem vírus como o Baculovírus, fungos entomopatogênicos como Metarhizium anisopliae, Beauveria bassiana e Isaria fumosorosea, além de parasitoides como Trichogramma pretiosum. Esses organismos têm demonstrado elevada eficácia no MIP, contribuindo para a manutenção da produtividade das culturas (Meyer et al., 2022).
É importante ressaltar que a maioria desses agentes biológicos é originária da natureza. Adotar estratégias de manejo que promovam a diversificação e o aumento da densidade populacional desses organismos nos sistemas de cultivo favorece a biodiversidade e melhora a qualidade biológica do solo. Além disso, o uso de produtos biológicos formulados com base nesses agentes proporciona respostas mais eficientes e rápidas no controle de pragas.
Além dos produtos biológicos empregados no manejo fitossanitário das culturas agrícolas, o uso de inoculantes têm se destacado por contribuir significativamente para o aumento do desempenho das plantas. Esta contribuição deve-se, em grande parte, ao papel dos inoculantes em fornecer através de associação com as plantas, nutrientes essenciais, como o nitrogênio, que tem papel crucial na produtividade.
Além disso, micronutrientes como cobalto (Co) e molibdênio (Mo) são fundamentais para a fixação biológica de nitrogênio (FBN) na soja, pois participam diretamente na formação e funcionamento das enzimas nitrogenase e redutase do nitrato, essenciais nesse processo. A adequada nutrição com esses elementos potencializa a FBN, resultando em maior disponibilidade de nitrogênio para a planta e, consequentemente, em incrementos na produtividade (Sfredo & Oliveira, 2010).
Nesse contexto, produtos como o DualForce, que combinam em uma única formulação as bactérias Azospirillum e Bradyrhizobium para a cultura da soja, e o MASTERfix para o milho, exemplificam soluções que, quando associadas a uma nutrição mineral balanceada, estimulam o crescimento e desenvolvimento radicular. Essas combinações aumentam a resiliência das plantas em condições de estresse, contribuindo para uma produção agrícola mais eficiente e sustentável.
Da mesma forma, o aporte de nutrientes como Zinco, Boro, Cobre e Manganês favorecem processos bioquímicos e metabólicos nas plantas, contribuindo para o aumento da síntese de lignina e de proteínas, além de favorecer o regulamento hormonal (IPNI, s. d.).
Microrganimos promotores de crescimento, são produtos microbiológicos que tem a capacidade de produzir hormonios vegetais, que entre outros efeitos, podem exercer o papel de modulores de crescimento, estimulando o crescimento da parte aérea, raízes, desenvolvimento de flores e frutos nas plantas. Entre os principais hormônios vegetais, destacam-se as auxinas, giberelinas (ácido giberélico), citocininas. Esses fitormônios geralmente atuam como promotores do crescimento das plantas; no entanto, em determinados períodos, sob a influência de estímulos fisiológicos ou ambientais, podem exercer outras funções específicas (Santos, 2024).
Tabela 1. Principais funções dos hormônios vegetais nas plantas

Estudos tem demonstrado que o uso de reguladores do crescimento vegetal tem contribuído efetivamente para o aumento da produtividade de culturas como a soja, exercendo influência positiva na formação de componentes de produtividade como peso de grãos, afetando consequentemente a produtividade final da cultura. De acordo com Barbosa et al. (2023) a produtividade da soja é elevada pelo uso de biorreguladores, em especial os que combinam em sua formulação, Citocinina, Giberelina e Auxina (Cinetina+GA3+AIB), desde que sejam adequadamente posicionados durante o desenvolvimento da soja.
Além da produção de reguladores de crescimento, alguns microrganimos podem atuar em outras atividades fisiológicas e metabólicas da planta, estimulando o crescimento vegetal e resiliência das plantas sob condições de estresse. Segundo Lacerda Junior & Melo (2022), por meio de relações simbióticas entre plantas e microrganismos, plantas sintetizam compostos utilizados para a nutrição microbiana associada, enquanto os microrganismos liberam hormônios vegetais, proteínas, mucilagens e compostos orgânicos voláteis que auxiliam no desenvolvimento das plantas, elevando sua capacidade a tolerar períodos de estresse hídrico.
Figura 4. . Ilustração dos mecanismos de tolerância à seca induzidos por rizobactérias promotoras de crescimento de plantas (RPCP). RPCP são capazes de produzir fitohormônios que influenciam na condutância estomática, crescimento e arquitetura das raízes. A atividade da enzima ACC deaminase bacteriana impacta a via de biossíntese do etileno, estimulando o crescimento radicular. A produção de exopolissacarídeos (EPS) e formação de biofilmes na superfície das raízes protegem as plantas do dessecamento, aumentando a absorção de água e nutrientes. Os osmólitos (e.g. prolina, betaína, ectoína e trealose) sintetizados protegem e estabilizam a membrana celular em condições de estresse hídrico, enquanto as enzimas antioxidantes (e.g. APX, SOD e CAT) combatem a produção de radicais livres (Lacerda Junior & Melo, 2022).
 Fonte: Lacerda Junior & Melo (2022)
Fonte: Lacerda Junior & Melo (2022)
Em outras palavras, os biorreguladores possuem a capacidade de interagir em processos fisiológicos das plantas, elevando a capacidade delas a resistir a condições de estresse, e aumentar a performance vegetal em prol do aumento da produtividade.
Em função da versatilidade de alguns organismos, a participação dos bioinsumos no manejo fitossanitário das culturas agrícolas tem ganhado espaço, especialmente no MIP. Fungos, bactérias e parasitoides, têm contribuído expressivamente para a redução da densidade de pragas de forma sustentável em lavouras agrícolas. De acordo com Meyer et al. (2022), bactérias, vírus, fungos entomopatogênicos, assim como alguns parasitoides (figura 5), podem ser utilizados no manejo de pragas para o controle de insetos e alguns fitonematoides. Dentro desse grupo, há uma grande diversidade de organismos que podem ser utilizados no MIP, desde que respeitadas suas aptidões e limitações para um controle eficiente das pragas.
Figura 5. Telenomus podisi parasitando ovos do percevejo Euschistus heros
 Foto: Adair Carneiro (Embrapa)
Foto: Adair Carneiro (Embrapa)
Além do controle de pragas, alguns biodefensivos podem ser utilizados no manejo de doenças e fitonematoides, como é o caso do Bacillus amyloliquefaciens, que apresenta aptidão para uso como antagonista de doenças, e segundo Salvadori et al. (2024), pode reduzir o crescimento c miceliar de C. sojina, C. cassicola, S. glycines e C. truncatum em 30%, 55%, 50% e 52% respectivamente. Outras espécies de bactérias e fungos a exemplo do Trichoderma também são empregados no manejo biológico de doenças.
Já com relação ao controle de fitonematoides, fungos quitinolíticos, como Purpureocillium lilacinum (syn. Paecilomyces lilacinus) e Pochonia chlamydosporia, além dos produtores de metabólitos tóxicos e indutores de resistência, como Trichoderma spp, destacam-se como ferramentas biológicas no manejo dessa praga. (Dias-Arieira et al., 2022). Quando empregados em soluções inteligentes como o Rizotec (Pochonia chlamydosporia), esse microrganismo pode reduzir significativamente a população de fitonematoides no solo, pois se alimenta de ovos e nematoides juvenis, tanto no solo quanto nas raízes das plantas, de forma endofítica.
A utilização dos Bioinsumos na agricultura brasileira e mundial vem crescendo ano após ano, impulsionado por fatores regulatórios, exigências de mercado e práticas de manejo agrícola.
Figura 6. Mercado de Bioinsumos comerciais (em Bi R$) no Brasil, nas últimas três safras
 Fonte: CropLife Brasil (2024)
Fonte: CropLife Brasil (2024)
A participação do mercado de Bioinsumos comerciais no valor de mercado total apresentou um crescimento de 30% considerando as últimas três safras. Já com relação a área cultivada, o aumento da adesão foi ainda mais expressivo, com crescimento de 50% na safra 2023/24 em relação à safra 2021/22, com a área tratada com bioinsumos correspondendo a 11% da área total cultivado (CropLife Brasil, 2024).
Figura 7. Área tratada com Bioinsumos (em mi ha) e participação dos biológicos na área total tratada no Brasil.
 Fonte: CropLife Brasil (2024)
Fonte: CropLife Brasil (2024)
Considerando a área tratada com Bioinsumos no Brasil, com maior participação, a soja representa 68%, seguida pelo milho (21%) e pela cana de açúcar (7%) (CropLife Brasil, 2024). O aumento da área tratada com Bioinsumos no Brasil demonstra o potencial dessas biotecnologias na agricultura.
Vale destacar que, em meio a diversidade de Bioinsumos disponíveis na atualidade para uso na agricultura, o posicionamento desses bioprodutos visando o aumento da performance vegetal nem sempre é uma tarefa fácil, sobretudo, além do adequado posicionamento desses produtos, é vital atentar para a qualidade dos Bioinsumos utilizados.
A Stoller por exemplo, é uma referência global em Bioinsumos, apresentando em seu portifólio soluções fisiológicas e biológicas que possibilitam o aumento da performance das plantas, sem por em risco a sanidade da lavoura. Com uma gama completa de soluções que atuam de forma sinérgica para suprir as necessidades fisiológicas das plantas nos variados estádios do seu desenvolvimento, a Stoller conta com Bioinsumos para culturas produtoras de grãos, cana-de-açúcar e hortifruti, atuando de maneira séria, com resultados reais que preconizam o aumento da performance vegetal.